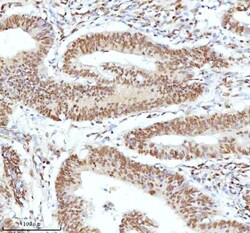
Invitrogen Ku70 Polyclonal Antibody 100 &mu;g; Unconjugated:Antibodies,

Learn More
Invitrogen™ Ku70 Polyclonal Antibody


Rabbit Polyclonal Antibody
Brand: Invitrogen™ PA595270
Description
Reconstitute with 0.2 mL of distilled water to yield a concentration of 500 μg/mL. Positive Control - WB: human LNCAP whole cell, human Hela whole cell, human 293T whole cell, human HepG2 whole cell, human Jurkat whole cell, human K562 whole cell, human A549 whole cell, human A431 whole cell. IHC: human bladder cancer tissue, human bladder cancer tissue, human colon adenocarcinoma tissue, human colon adenocarcinoma tissue, human glioblastoma tissue, human glioblastoma tissue, human liver cancer tissue, human liver cancer tissue, human lung adenocarcinoma tissue, human lung adenocarcinoma tissue, human pancreas ductal adenocarcinoma tissue, human pancreas ductal adenocarcinoma tissue, human testicular seminoma tissue, human testicular seminoma tissue. ICC/IF: U2OS cell. Flow: A431 cell. Store at -20°C for one year from date of receipt. After reconstitution, at 4°C for one month. It can also be aliquotted and stored frozen at -20°C for six months. Avoid repeated freeze-thaw cycles.
XRCC6 is a nuclear complex consisting of two subunits with molecular masses of approximately 70 and 80 kDa. The complex functions as a single-stranded DNA-dependent ATP-dependent helicase. The complex may be involved in the repair of nonhomologous DNA ends such as that required for double-strand break repair, transposition, and V(D)J recombination. High levels of autoantibodies to p70 and p80 have been found in some patients with systemic lupus erythematosus.
Specifications
| Ku70 | |
| Polyclonal | |
| Unconjugated | |
| XRCC6 | |
| 5'-deoxyribose-5-phosphate lyase Ku70; 5'-dRP lyase Ku70; 5'-dRP/AP lyase Ku70; 70 kDa subunit of Ku antigen; 70kDa; ATP-dependent DNA helicase 2 subunit 1; ATP-dependent DNA helicase II 70 kDa subunit; ATP-dependent DNA helicase II, 70 kDa subunit; CT; CTA-216E10.7; CTC box binding factor 75 kDa subunit; CTC box-binding factor 75 kDa subunit; CTC75; CTCBF; DNA repair protein XRCC6; G22p1; Ku autoantigen p70 subunit; ku autoantigen protein p70 homolog; Ku autoantigen, 70kDa; Ku p70; Ku70; Ku70 DNA-binding component of DNA-dependent proteinkinase complex (thyroid autoantigen 70 kDa); Kup70; Lupus Ku autoantigen protein p70; ML8; OTTHUMP00000028581; thyroid autoantigen; thyroid autoantigen 70 kDa; thyroid autoantigen 70kD (Ku antigen); thyroid autoantigen 70kDa (Ku antigen); Thyroid-lupus autoantigen; thyroid-lupus autoantigen p70; TLAA; XELAEV_18023498mg; X-ray repair complementing defective repair in Chinese hamster cells 6; X-ray repair complementing defective repair in Chinese hamster cells 6 L homeolog; X-ray repair cross complementing 6; X-ray repair cross-complementing protein 6; xrcc6; xrcc6.L | |
| Rabbit | |
| Affinity chromatography | |
| RUO | |
| 2547 | |
| -20°C | |
| Lyophilized |
| Flow Cytometry, Immunohistochemistry (Paraffin), Western Blot, Immunocytochemistry | |
| 500 μg/mL | |
| PBS with 5mg BSA and 0.05mg sodium azide | |
| P12956 | |
| XRCC6 | |
| A synthetic peptide corresponding to a sequence at C-terminus of human Ku70 (464-496aa AIVEKLRFTYRSDSFENPVLQQHFRNLEALALD). | |
| 100 μg | |
| Primary | |
| Human | |
| Antibody | |
| IgG |
Your input is important to us. Please complete this form to provide feedback related to the content on this product.